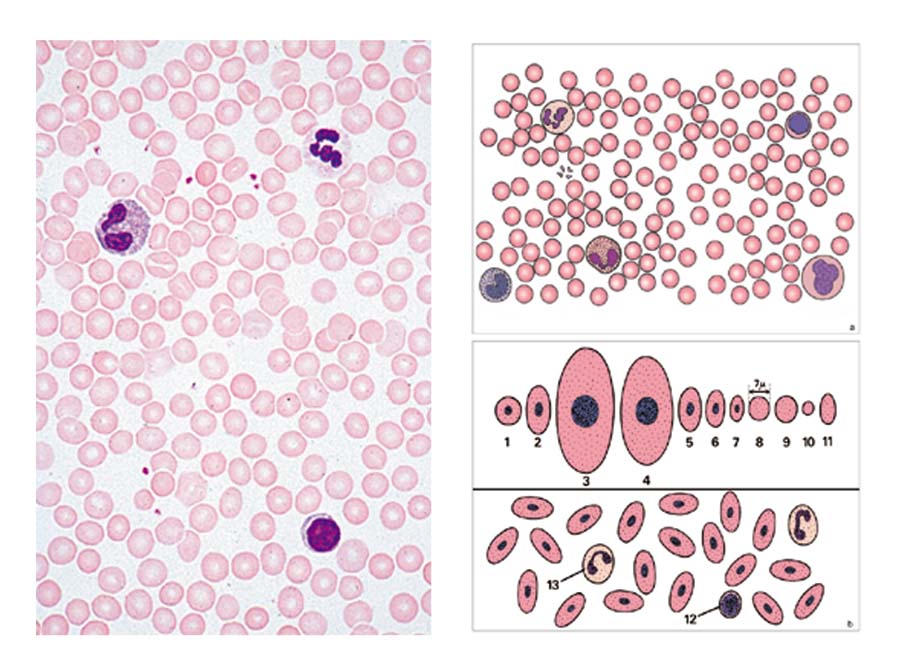

Präparate – Allgemeinwissen Mikroskopie
Lieferzeit: ca. 4-6 Wochen (Saisonbedingt)
Artikelnummer:
5504830
Kategorie: Multimedia-Pakete
Stichworte: Multimedia-Pakete, Mikroskopie, Präparate - Allgemeinwissen Mikroskopie, Biologie
Basispaket mit 6 Einheiten
als Lehrer- oder Schülerpaket
Erlaeuterung-Multimedia-Pakete.pdf
78.42€ – 114.95€
1. Buchstabe „e“ – 2. Stubenfliege, Bein total – 3. Pieris, Schmetterling, Stück vom Flügel mit Schuppen –
4. Blut vom Menschen, Ausstrich – 5. Pflanzenzellen, Holundermark, quer – 6. Farbige Textilfasern w.m.
Multimedia-Lehrerpaket
6 Mikropräparate im Plastikkasten,
3 farbige Overhead Transparente,
6 Arbeits- und Zeichenblätter als Kopiervorlagen, Textheft mit Erläuterungen, Aufbewahrungskarton
Multimedia-Schülerpaket
6 Mikropräparate im Plastikkasten, Textheft mit Erläuterungen, Aufbewahrungskarton.
| Ausführung anklicken | Lehrerpaket, Schülerpaket |
|---|